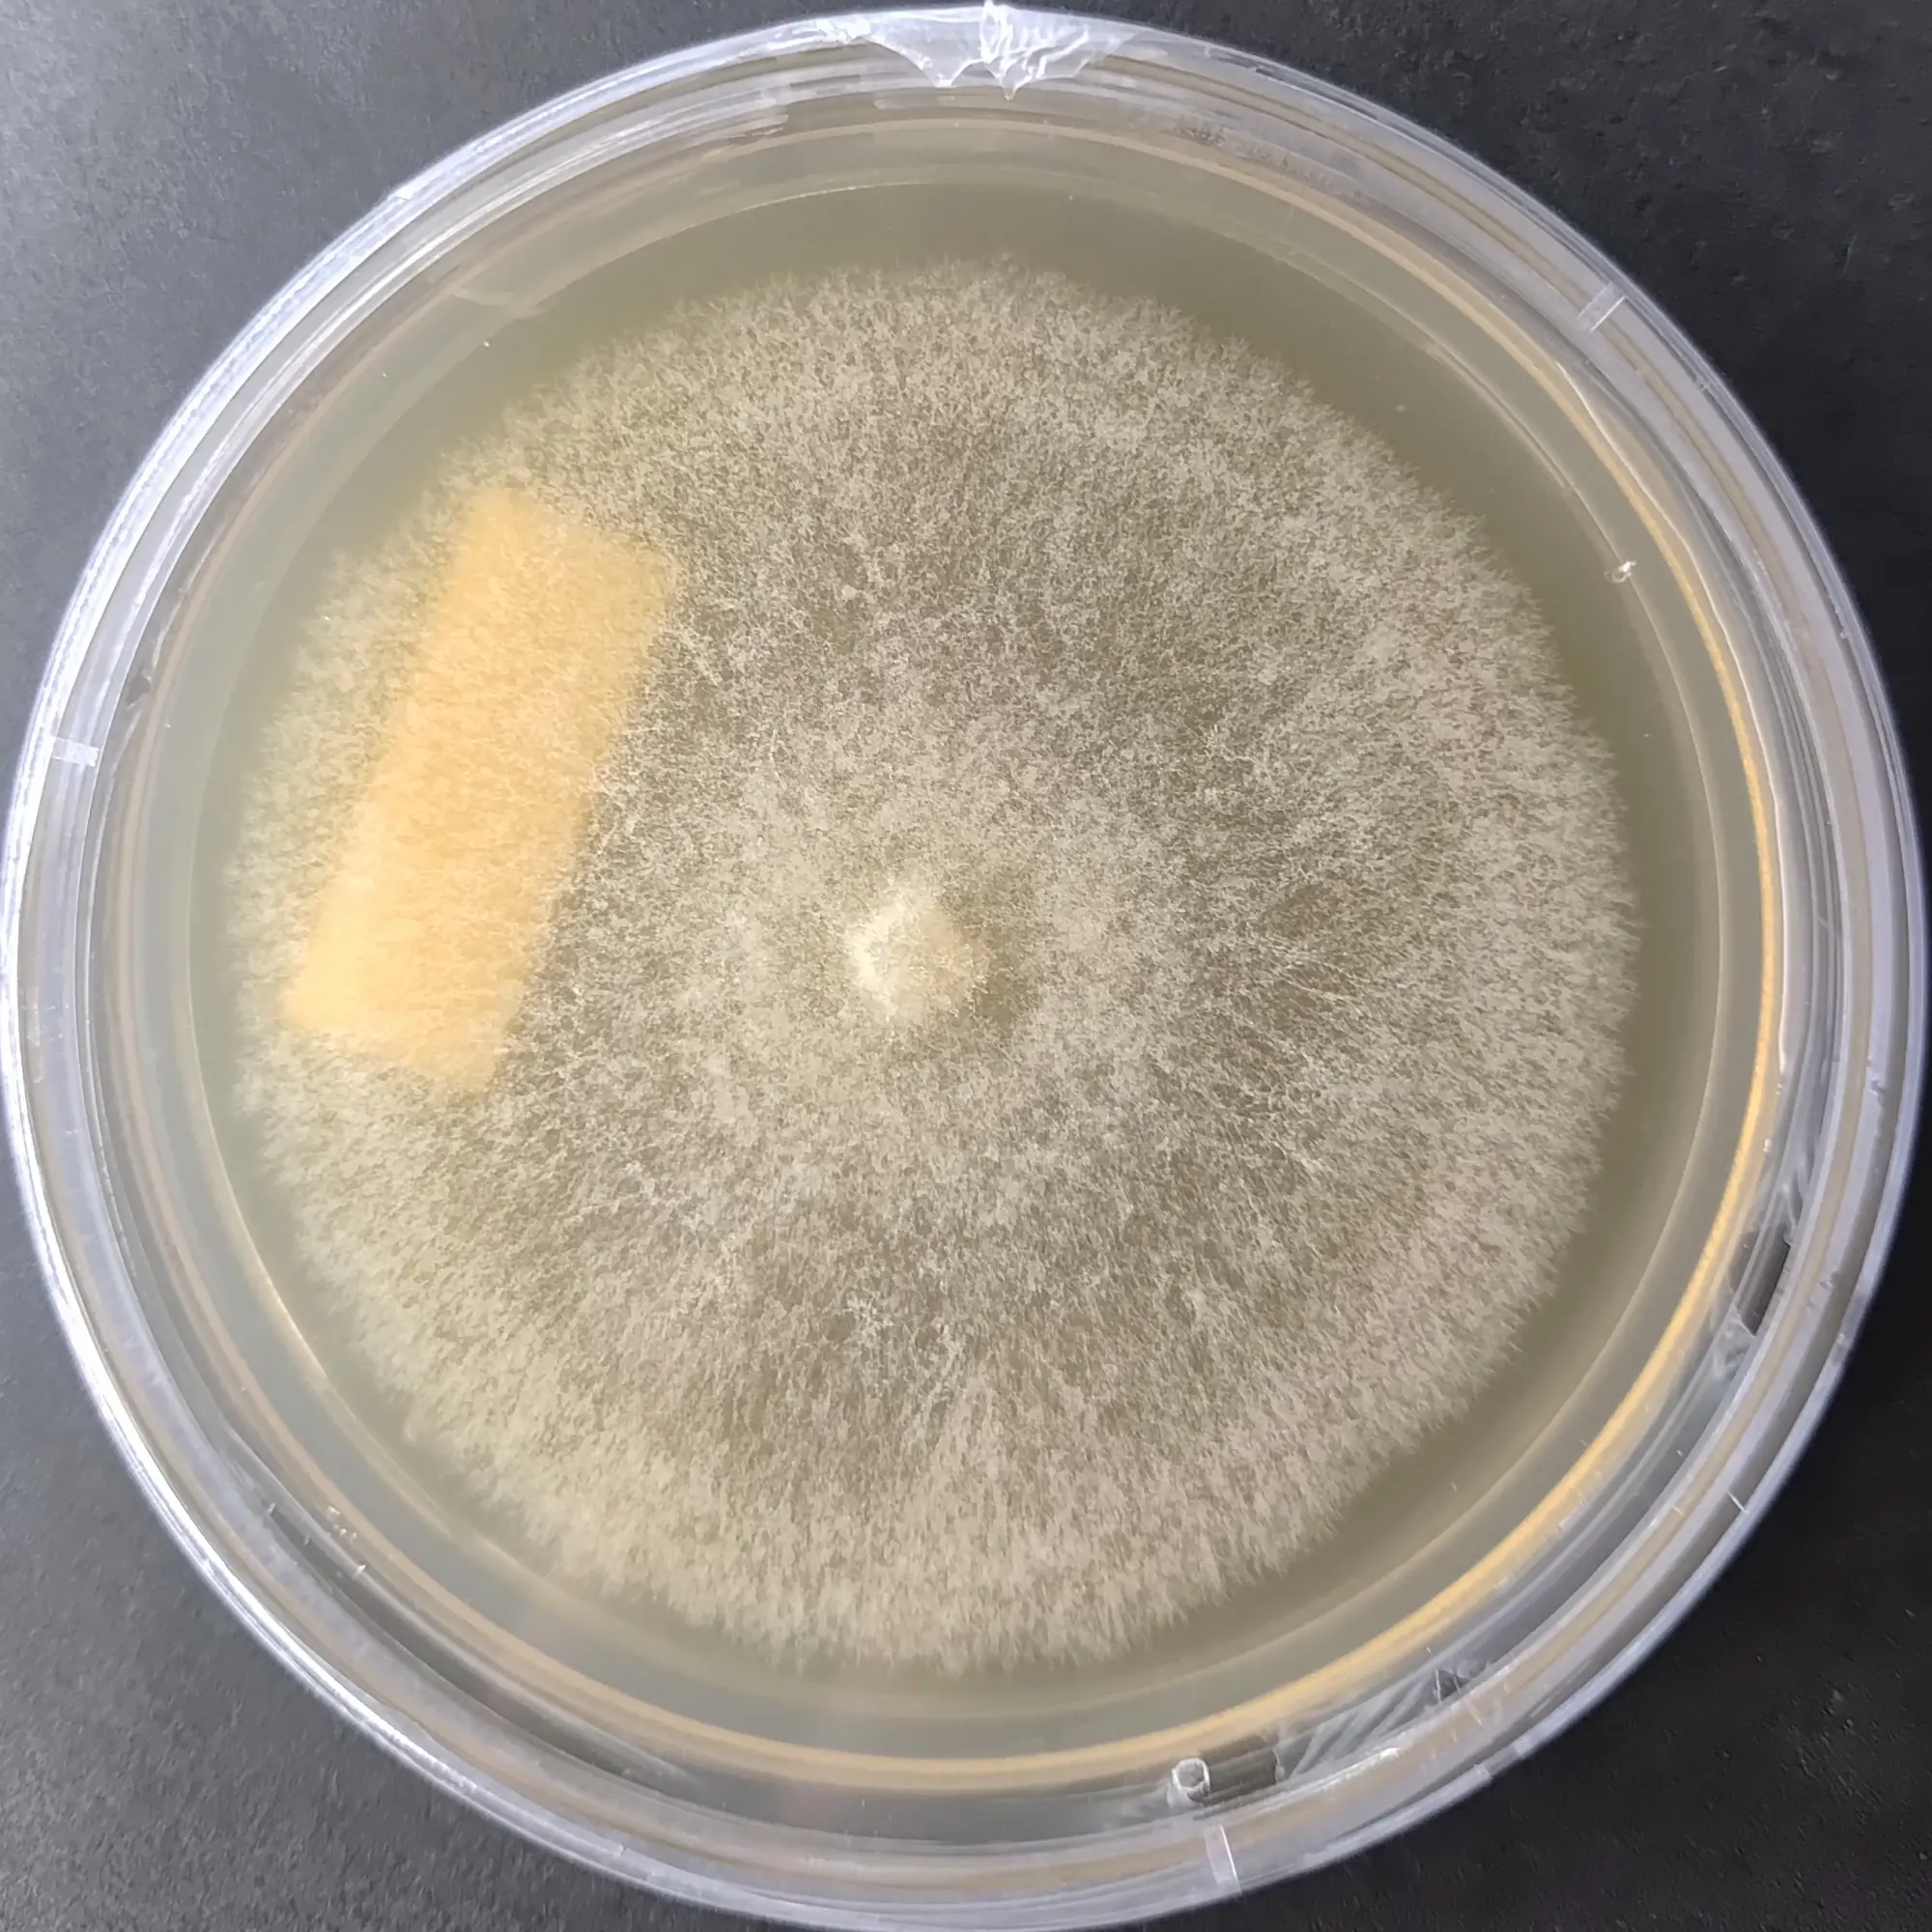
F110 L zonatus.webp

Giant Puffball Mushroom Culture (Langermannia gigantea)
₹2,500.00
You’re now subscribed to price tracking for this product. We’ll notify you if the price drops.
Langermannia gigantea, commonly known as the Giant Puffball Mushroom, is one of the largest known edible fungi, renowned for its massive spherical fruiting bodies and rapid biomass formation. Beyond its culinary interest, the species is widely studied for fungal development, sporulation biology, and ecological research.
This Giant Puffball Mushroom Culture Plate contains a laboratory-isolated, contamination-free pure culture, maintained under controlled conditions to ensure active mycelial growth and genetic stability. The culture is suitable for mycological research, strain maintenance, substrate trials, and educational laboratories. Due to limited standardized cultivation protocols, it is primarily recommended for experimental and research-oriented use.
Agripie’s cultures are preserved in a controlled culture bank, ensuring reliability, traceability, and consistency across rare and specialty mushroom species.
Key Features
-
Species: Langermannia gigantea
-
Common Name: Giant Puffball Mushroom
-
Culture Type: Pure mycelial culture on agar plate
-
Plate Size: 90 mm Petri plate
-
Mycelium Quality: Actively growing, contamination-free
Storage & Handling Guidelines
-
4Avoid freezing or exposure to excessive heat
-
Handle and subculture only under aseptic conditions
-
Best used within 3 months for optimal vigor
Important Note
Langermannia gigantea is a wild-type species with variable growth behavior. Fruiting success and growth characteristics may vary significantly depending on substrate composition and environmental conditions.
🍄 Proudly prepared and stored at Agripie Agrosystem LLP, India 🇮🇳
| Weight | 0.1 g |
|---|
Only logged in customers who have purchased this product may leave a review.

Reviews
There are no reviews yet.